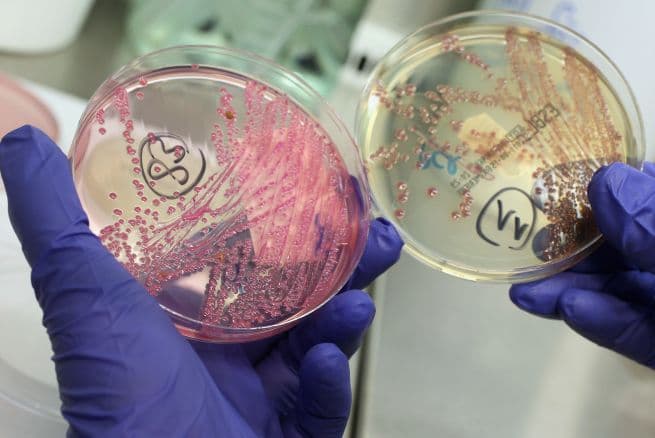
Investigan el origen de un nuevo brote de E. coli que ya afecta a 5 estados

E. coli
E. coli: Últimas noticias, videos y fotos de E. coli
LO MÁS RECIENTE
Niño de dos años de familia hispana muere por E. coli después de visitar la granja de una feria en San Diego
Otros tres pequeños que estuvieron en contacto con los animales de esa granja también enfermaron. Las autoridades sanitarias recuerdan la importancia del lavado de manos y otras medidas que son fundamentales en el cuidado de la salud de los menores.

Retiran 14,000 paquetes de esta harina por posible contaminación con E. coli
Los paquetes de 5 libras de la marca King Arthur Flour han sido distribuidos por todo el país, sobre todo en Walmart y Target. Si usted compró uno de estos paquetes debe regresarlos y pedir el dinero de vuelta.
¿Qué vas a comer este Memorial Day? La FDA retira carne del mercado por la presencia de E. coli
La Administración Federal de Medicamentos y Alimentos está retirando 62 mil libras de carne cruda en todo el país por la presencia de la bacteria. No se han reportado personas enfermas por este caso, pero es importante seguir las instrucciones de las autoridades para evitarlo.

Retiran del mercado 62,000 libras de carne por sospecha de infección de E. Coli
Decenas de miles de libras que incluyen más de 40 tipos de cortes de carne han sido retirados del mercado por la empacadora que ha exportado sus productos desde Illinois.

Deja de lavar tu pollo crudo, es peligroso para la salud: La recomendación de autoridades sanitarias
Un tuit del Centro para el Control y Prevención de enfermedades (CDC) subrayaba que el pollo crudo no debe lavarse antes de cocinarse y ese anuncio causó controversia entre internautas, pero la explicación de los expertos de la agencia es muy razonable. Te explicamos.
Más de 160,000 libras de carne molida son retiradas del mercado por contaminación con E. coli
Ya suman 177 casos reportados, de los cuales 21 han terminado en hospitalizaciones. Los afectados tienen entre 1 y 84 años, y consumieron carne de res desde el 1 de marzo.